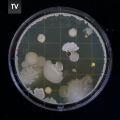

La ricerca sarà presto disponibile in italiano, per favore scrivi in Inglese.
| 专辑 | 曲名 | Vers. | 分轨文件 | 时长 | 作曲/艺术家 | 描述 | 关键词 | Key | BPM | ||
|---|---|---|---|---|---|---|---|---|---|---|---|

|
Disarm [CEG5058 - 6] |
0 | 1'03 | Les Cosmonotes | Minimal Clockwork. Waiting, hesitant, odd & glitchy. Clockwork FX, | (音效)滴答声 奇怪 沉重 机械的 神经病 进行中 固执 冲击 声音设计 悬念 | Abm | 150 |
|
||

|
Fact Finding [TBX184 - 5] |
2'03 | Jack Pierce | Lively, majestic, curious. Plucked strings play out an inquisitive | 果断 疑问 调查研究 悲喜剧 新古典音乐 严谨 时间(滴答声) 紧急 周期性的 神秘 | Dm | 149 |
|
|||

|
Fact Finding (Underscore No
[TBX184 - 20] |
版本. | 2'03 | Jack Pierce | Lively, majestic, curious. Plucked strings play out an inquisitive | 果断 疑问 调查研究 悲喜剧 新古典音乐 严谨 时间(滴答声) 紧急 周期性的 神秘 | Dm | 149 |
|
||

|
Fact Finding (Underscore
[TBX184 - 21] |
版本. | 2'03 | Jack Pierce | Lively, majestic, curious. Plucked strings play out an inquisitive | 果断 疑问 调查研究 悲喜剧 新古典音乐 严谨 时间(滴答声) 紧急 周期性的 神秘 | Dm | 99 |
|
||

|
A Minor Hitch [CEZ4671 - 1] |
1'06 | Emma Jackson | Dramedy. Elegant, reflective & investigative. Double bass, cello & | 疑问 light tension 悲喜剧 反省 伴音 叙述 耐心 稳定的 进行中 阴险 | Fm | 120 |
|
|||

|
A Minor Hitch Alternate [CEZ4671 - 17] |
版本. | 1'06 | Emma Jackson | Underscore version | 疑问 light tension 悲喜剧 反省 伴音 叙述 耐心 稳定的 进行中 阴险 | Fm | 120 |
|
||

|
Echoes of Marimba [CEZ4647 - 1] |
1'41 | Wolfgang Lackerschmid, Andreas Suttner | Suspended, questioning, repetitive & narrative. Marimba with delay | 马林巴琴 疑问 自然 科学 时间(滴答声) 进行中 精致 神秘 悬念 明朗 | Bb | 125 |
|
|||

|
Echoes of Marimba Alternate 1 [CEZ4647 - 13] |
版本. | 1'41 | Wolfgang Lackerschmid, Andreas Suttner | Minimal version without synth | 疑问 马林巴琴 科学 进行中 神秘 明朗 自然 自信 周期性的 叙述 | Bb | 125 |
|
||

|
Echoes of Marimba Alternate 2 [CEZ4647 - 14] |
版本. | 1'41 | Wolfgang Lackerschmid, Andreas Suttner | Minimal version marimba only | 疑问 马林巴琴 科学 进行中 神秘 明朗 自然 自信 独奏 周期性的 | Bb | 125 |
|
||

|
Echoes of Marimba Edit 1
[CEZ4647 - 15] |
版本. | 1'00 | Wolfgang Lackerschmid, Andreas Suttner | 60 second cut | 疑问 马林巴琴 科学 进行中 神秘 明朗 自然 自信 周期性的 延迟 | Bb | 125 |
|
||

|
Echoes of Marimba Edit 2
[CEZ4647 - 16] |
版本. | 0'30 | Wolfgang Lackerschmid, Andreas Suttner | 30 second cut | 疑问 马林巴琴 科学 进行中 神秘 明朗 自然 自信 周期性的 延迟 | Fm | 124 |
|
||

|
Echoes of Marimba Edit 3
[CEZ4647 - 17] |
版本. | 0'15 | Wolfgang Lackerschmid, Andreas Suttner | 15 second cut | 疑问 马林巴琴 科学 进行中 神秘 明朗 自然 自信 周期性的 延迟 | Bb | 125 |
|
||

|
Rogue Recon [TBX231 - 7] NEW |
2'25 | James Tearne | Daring, thrilling, powerful. Whirring fuzzy drone note offers an | 嗡嗡声 悬念 司法 恐怖片 间谍片 令人不安 时间(滴答声) 稳定的 无情 阴险 | D | 100 |
|
|||

|
Rogue Recon (Underscore) [TBX231 - 21] |
版本. | 2'25 | James Tearne | Daring, thrilling, powerful. Whirring fuzzy drone note offers an | 嗡嗡声 悬念 司法 恐怖片 间谍片 令人不安 时间(滴答声) 稳定的 无情 阴险 | D | 100 |
|
||

|
Mischievous Phenomenon
[CEZ4484 - 34] |
2'11 | Anselm Kreuzer, Andreas Suttner | Minimalist alternate version. Teasing, careful, conscientious & | 周期性的 稀疏 科学 伴音 疑问 耐心 悲喜剧 进行中 调查研究 医疗 | Fm | 119 |
|
|||

|
Mischievous Phenomenon [CEZ4484 - 11] |
版本. | 2'11 | Anselm Kreuzer, Andreas Suttner | Teasing, careful, conscientious & deceptively mysterious almost | 周期性的 科学 伴音 疑问 耐心 悲喜剧 进行中 调查研究 医疗 神秘 | Fm | 60 |
|
||

|
Investigating Smartly [CEZ4671 - 4] |
1'41 | Julien Vega | Light Tension / Dramedy. Cautious & mysterious with a light suspense. | 悲喜剧 疑问 阴险 进行中 light tension 悬念 时间(滴答声) 神秘 调查研究 机械的 | Dm | 130 |
|
|||

|
Investigating Smartly
[CEZ4671 - 21] |
版本. | 1'35 | Julien Vega | Underscore version | 悲喜剧 疑问 阴险 进行中 light tension 悬念 时间(滴答声) 神秘 调查研究 机械的 | Dm | 130 |
|
||

|
Agitating Suspense (Alt
[TBX151 - 13] |
1'48 | Jack Pierce | Playful, curious, silly. Nervy strings create a sense of anticipation | 耐心 悲喜剧 阴险 严谨 悬念 日间节目 令人不安 疑问 调查研究 政治 | Dbm | 116 |
|
|||

|
Agitating Suspense [TBX151 - 1] |
版本. | 1'48 | Jack Pierce | Playful, curious, silly. Clock percussive FX meet with nervy strings | 竞猜节目 耐心 时间(滴答声) 悲喜剧 阴险 严谨 悬念 (音效)滴答声 令人不安 疑问 | Dbm | 117 |
|
||

|
Getting To The Bottom Of It [TBX224 - 8] |
2'06 | Edoardo Bombace, Luca Uggias | Smart, intricate, serious. Pillowy Bell's push out with breathy | 疑问 light tension 阴险 调查研究 神秘 严谨 科学 周期性的 夜晚 固执 | Dm | 142 |
|
|||

|
Getting To The Bottom Of It
[TBX224 - 27] |
版本. | 2'06 | Edoardo Bombace, Luca Uggias | Smart, intricate, serious. Pillowy Bell's push out with breathy | 疑问 light tension 阴险 调查研究 神秘 严谨 科学 周期性的 夜晚 固执 | Dm | 142 |
|
||

|
Getting To The Bottom Of It
[TBX224 - 28] |
版本. | 2'06 | Edoardo Bombace, Luca Uggias | Smart, intricate, serious. Pillowy Bell's push out with breathy | 疑问 light tension 阴险 调查研究 神秘 严谨 科学 周期性的 夜晚 固执 | Dm | 142 |
|
||

|
Curiosity [CEZ4640 - 1] |
2'08 | Laurent Dury | Dramedy. Curious, bouncy & mischievous. Marimba, piano & small percs. | 马林巴琴 悲喜剧 神秘 进行中 阴险 调查研究 竞猜节目 科学 疑问 宠物 | Dm | 120 |
|
|||

|
Curiosity Alternate [CEZ4640 - 12] |
版本. | 2'09 | Laurent Dury | Alternate version. Marimba & vibes. | 马林巴琴 悲喜剧 神秘 进行中 阴险 调查研究 竞猜节目 科学 疑问 电颤琴 | Dm | 120 |
|
||

|
How Unfortunate [CEZ4671 - 2] |
2'01 | Jack Pierce | Dramedy. Stealthy & cunning with a light suspense. Clarinet bass, | 阴险 悲喜剧 讽刺 & 恶意 疑问 light tension 严谨 稳定的 进行中 竞猜节目 神秘 | Abm | 97 |
|
|||

|
How Unfortunate Alternate 1 [CEZ4671 - 18] |
版本. | 2'01 | Jack Pierce | Underscore version | 阴险 悲喜剧 讽刺 & 恶意 疑问 light tension 严谨 稳定的 进行中 竞猜节目 神秘 | Ab | 97 |
|
||

|
How Unfortunate Alternate 2 [CEZ4671 - 19] |
版本. | 2'01 | Jack Pierce | Underscore version | 阴险 悲喜剧 讽刺 & 恶意 疑问 light tension 严谨 稳定的 进行中 竞猜节目 神秘 | Abm | 97 |
|
||

|
Chop Chop [CEZ4592 - 2] |
1'53 | Thomas Didier | Suspenseful, ticking bed. Playful, light & mischievous. Accelerando @ | 耐心 时间(滴答声) 竞猜节目 周期性的 悲喜剧 疑问 light tension 马林巴琴 严谨 悬念 | C | 115 |
|
|||

|
Chop Chop Alternate [CEZ4592 - 17] |
版本. | 1'53 | Thomas Didier | Alternate no percussion. | 竞猜节目 耐心 周期性的 悲喜剧 疑问 light tension 马林巴琴 严谨 悬念 时间(滴答声) | C | 115 |
|
||

|
Like An Anomaly [CEZ4618 - 2] |
2'36 | Thomas Lucas | Minimal Electro / Investigation. Intriguing, suspenseful, sequenced & | 调查研究 进行中 疑问 神秘 夜晚 固执 信息技术 周期性的 果断 科学 | Bm | 89 |
|
|||

|
Like An Anomaly Alternate [CEZ4618 - 11] |
版本. | 2'34 | Thomas Lucas | Alternate without percussion. | 调查研究 进行中 疑问 神秘 夜晚 固执 信息技术 周期性的 果断 科学 | Bm | 90 |
|
||

|
Branches Of Progress [TBX224 - 5] |
2'18 | Edoardo Bombace, Luca Uggias | Extraordinary, mystifying, positive. Bright Bell's search out in a | 疑问 科学 果断 light tension 神秘 耐心 自信 设计与建筑 调查研究 马林巴琴 | Ebm | 96 |
|
|||

|
Branches Of Progress
[TBX224 - 21] |
版本. | 2'18 | Edoardo Bombace, Luca Uggias | Extraordinary, mystifying, positive. Bright Bell's search out in a | 疑问 科学 果断 light tension 神秘 耐心 自信 设计与建筑 调查研究 马林巴琴 | Ebm | 96 |
|
||

|
Branches Of Progress
[TBX224 - 22] |
版本. | 2'18 | Edoardo Bombace, Luca Uggias | Extraordinary, mystifying, positive. Bright Bell's search out in a | 疑问 科学 果断 light tension 神秘 耐心 自信 设计与建筑 调查研究 马林巴琴 | Ebm | 96 |
|
||

|
Working Time [CEZ4566 - 14] |
1'49 | Sebastian Dierksen, Louis Edlinger | Suspended, patient, steady & minimalist. Electronics with delay & | 悬念 稀疏 原声电子 耐心 科学 稳定的 调查研究 严谨 气氛 信息技术 | Am | 109 |
|
|||

|
Working Time Alternate 1 [CEZ4566 - 56] |
版本. | 1'49 | Sebastian Dierksen, Louis Edlinger | Destructured alternate version | 悬念 稀疏 原声电子 耐心 科学 稳定的 严谨 气氛 信息技术 极简电子音乐 | Am | 109 |
|
||

|
Working Time Alternate 2 [CEZ4566 - 57] |
版本. | 1'49 | Sebastian Dierksen, Louis Edlinger | Alternate version (light percussion & FX only) | 稀疏 原声电子 科学 稳定的 调查研究 耐心 信息技术 极简电子音乐 严谨 低沉 | A | 109 |
|
||

|
Working Time Alternate 3 [CEZ4566 - 58] |
版本. | 1'49 | Sebastian Dierksen, Louis Edlinger | Sparse alternate version. | 稀疏 无声 悬念 耐心 原声电子 严谨 科学 气氛 极简电子音乐 疑问 | A | 109 |
|
||

|
So What? [CEZ4320 - 9] |
0 | 1'51 | Gréco Casadesus | TV series. Daily life. Time passing. Interrogative & patient. Pizz, | 疑问 拨奏 手工业 耐心 企业宣传 调查研究 机械的 政治 light tension 好玩 | Em | 94 |
|
||

|
Equations [CEZ4618 - 3] |
0 | 2'43 | Borussia | Minimal Electro / Investigation. Thoughtful, investigative, | 疑问 耐心 周期性的 反省 调查研究 神秘 进行中 竞猜节目 固执 时间(滴答声) | Ebm | 165 |
|
||

|
Chance and Necessity Alternate [CEZ4484 - 23] |
1'59 | Louis Edlinger, Anselm Kreuzer, Andreas Suttner | Minimalist alternate version. Bright, cyclic, reflective, shimmering | 疑问 周期性的 进行中 叙述 科学 伴音 神秘 耐心 间谍片 调查研究 | F | 115 |
|
|||

|
Chance and Necessity [CEZ4484 - 1] |
版本. | 1'59 | Louis Edlinger, Anselm Kreuzer, Andreas Suttner | Obstinate, intriguing & questioning, almost dramedy. Double bass, | 进行中 疑问 周期性的 叙述 科学 伴音 神秘 耐心 间谍片 调查研究 | C | 116 |
|
||

|
Solving the Crime [CEZ4592 - 6] |
1'38 | Thomas Didier | Suspenseful, ticking bed. Mysterious, nocturne & patient. Synth & | 进行中 调查研究 耐心 时间(滴答声) 催眠 神秘 科学 电子琴 伴音 稳定的 | Ebm | 112 |
|
|||

|
Solving the Crime Alternate [CEZ4592 - 20] |
版本. | 1'38 | Thomas Didier | Alternate no clock fx. | 催眠 神秘 时间(滴答声) 耐心 科学 电子琴 伴音 稳定的 调查研究 light tension | Ebm | 112 |
|
||

|
Shift of the Motion Alternate [CEZ4521 - 53] |
2'17 | Benoit Cimbé | Minimalist & neutral alternate version. | 耐心 科学 环境 周期性的 进行中 医疗 疑问 light tension 神秘 中立 | Em | 120 |
|
|||

|
Shift of the Motion [CEZ4521 - 18] |
版本. | 2'18 | Benoit Cimbé | Thoughtful, repetitive & soft electronic track with synth, percussion | 耐心 科学 环境 周期性的 进行中 医疗 疑问 light tension 神秘 中立 | Em | 119 |
|
||

|
A Day as Usual [CEZ4485 - 1] |
0 | 1'54 | Benjamin Doherty | Confident but slightly concerned. Intriguing & cyclic. Pizzicato | 手工业 独立电影 迷人 命运 疑问 内心 自信 进行中 自然 拨奏 | Bm | 130 |
|
||

|
Be Careful Please [CEZ4428 - 9] |
01'47 | Anselm Kreuzer, Andreas Suttner | Neutral, investigative, tinkling, questioning & a bit quirky. Piano, | 疑问 调查研究 耐心 电子键盘 进行中 叙述 中立 伴音 悲喜剧 悬念 | D | 67 |
|
|||

|
Be Careful Please [Alternate] [CEZ4428 - 42] |
版本. | 01'47 | Anselm Kreuzer, Andreas Suttner | Sparse alternate. Neutral, investigative, questioning & a bit quirky. | 进行中 耐心 疑问 悲喜剧 阴险 不稳定 调查研究 light tension 神秘 打击乐 | D | 68 |
|
||

|
Be Careful Please [Alternate
[CEZ4428 - 43] |
版本. | 01'47 | Anselm Kreuzer, Andreas Suttner | Alternate piano & chimes. Neutral, investigative, questioning & a bit | 进行中 耐心 疑问 悲喜剧 阴险 不稳定 调查研究 light tension 神秘 打击乐 | D | 67 |
|
||

|
Be Careful Please [Alternate
[CEZ4428 - 44] |
版本. | 01'47 | Anselm Kreuzer, Andreas Suttner | Alternate rhythm only. Neutral, investigative, questioning & a bit | 进行中 耐心 疑问 悲喜剧 阴险 不稳定 调查研究 light tension 神秘 打击乐 | Dm | 68 |
|
||

|
Be Careful Please [Alternate
[CEZ4428 - 45] |
版本. | 01'47 | Anselm Kreuzer, Andreas Suttner | Alternate piano only. Neutral, investigative, questioning & a bit | 进行中 耐心 疑问 悲喜剧 阴险 不稳定 调查研究 light tension 神秘 时间(滴答声) | D | 67 |
|
||

|
Awaiting Responses [CEZ4484 - 14] |
1'53 | Anselm Kreuzer, Andreas Suttner | At the same time woolly & luminous, interrogative & punctuated. Cello | 中立 科学 叙述 伴音 疑问 神秘 气氛 反省 明朗 医疗 | E | 114 |
|
|||

|
Awaiting Responses Alternate [CEZ4484 - 37] |
版本. | 1'53 | Anselm Kreuzer, Andreas Suttner | Minimalist alternate version. At the same time cottony & luminous, | 中立 科学 稀疏 叙述 伴音 疑问 神秘 气氛 反省 明朗 | E | 114 |
|
||

|
What Do You Think? [CEZ4320 - 1] |
0 | 2'01 | Baptiste Thiry | TV series. Daily life. Interrogative & confident. Piano, harp & | 疑问 企业宣传 手工业 自信 调查研究 叙述 日常生活 乡村 科学 琶音 | Ebm | 88 |
|
||

|
Data Science Mystery
[CEZ4533 - 35] |
2'15 | Louis Edlinger | Minimalist alternate version. Pulsation & percussion only. | 稀疏 pulsation 耐心 伴音 稳定的 疑问 夜晚 科学 警匪片 调查研究 | Dm | 115 |
|
|||

|
Data Science Mystery [CEZ4533 - 9] |
版本. | 2'22 | Louis Edlinger | Underscore/bed. Organic electro. Suspended, quiet, narrative, | 信息技术 通透 疑问 调查研究 稳定的 神秘 叙述 原声电子 sequencing 科学 | Am | 115 |
|
||

|
An Uncertain Diagnosis
[CEZ4484 - 44] |
1'56 | Louis Edlinger, Anselm Kreuzer, Andreas Suttner | Minimalist alternate version. Hesitant, questioning, irregular & | 周期性的 科学 电声低音 稳定的 疑问 调查研究 进行中 稀疏 反省 light tension | D | 100 |
|
|||

|
An Uncertain Diagnosis [CEZ4484 - 16] |
版本. | 1'56 | Louis Edlinger, Anselm Kreuzer, Andreas Suttner | Hesitant, questioning, irregular & suspenseful. Electric bass, | 周期性的 科学 电声低音 稳定的 疑问 调查研究 进行中 反省 light tension 耐心 | D | 100 |
|
||

|
Soft Rain Alternate [CEZ4521 - 51] |
1'56 | Benjamin Doherty | Minimalist & neutral alternate version. | 稀疏 中立 下雨 环境 疑问 神秘 从容 科学 精致 乡村 | G | 107 |
|
|||

|
Soft Rain [CEZ4521 - 16] |
版本. | 1'48 | Benjamin Doherty | Linear, peaceful, neutral & repetitive ambient track with synth | 中立 环境 稀疏 疑问 神秘 从容 下雨 科学 乡村 悬念 | G | 107 |
|
||

|
Furtively [CEZ4370 - 10] |
1'41 | Anselm Kreuzer, Andreas Suttner | Dramedy / underscore. Like in a dramedy scene. Hesitating, sparse & | 疑问 悲喜剧 稀疏 调查研究 神秘 伴音 悬念 马林巴琴 叙述 耐心 | Am | 60 |
|
|||

|
Furtively Alternate [CEZ4370 - 48] |
版本. | 1'41 | Anselm Kreuzer, Andreas Suttner | Dramedy / underscore. Like in a dramedy scene. Hesitating, sparse & | 悲喜剧 疑问 调查研究 神秘 伴音 悬念 稀疏 马林巴琴 叙述 耐心 | Am | 60 |
|
||

|
Furtively Alternate 2 [CEZ4370 - 49] |
版本. | 1'41 | Anselm Kreuzer, Andreas Suttner | Dramedy / underscore. Like in a dramedy scene. Hesitating, sparse & | 自然灾害 悲喜剧 疑问 地理政治 神秘 伴音 调查研究 叙述 耐心 悬念 | Am | 60 |
|
||

|
Furtively Alternate 3 [CEZ4370 - 50] |
版本. | 1'41 | Anselm Kreuzer, Andreas Suttner | Underscore. Like in a dramedy scene. Hesitating, sparse & | 伴音 稀疏 耐心 自然灾害 悬念 地理政治 疑问 叙述 科学 悬念 | Am | 118 |
|
||

|
One Step Forward, One Step
[CEZ4484 - 43] |
1'36 | Louis Edlinger, Anselm Kreuzer, Andreas Suttner | Minimalist alternate version. Investigative, ironic & discreet almost | 稀疏 light tension 疑问 耐心 调查研究 悲喜剧 科学 稳定的 进行中 讽刺 & 恶意 | Gm | 105 |
|
|||

|
One Step Forward, One Step
[CEZ4484 - 20] |
版本. | 1'36 | Louis Edlinger, Anselm Kreuzer, Andreas Suttner | Investigative, ironic & discreet almost dramedy. Electro percussion, | 稳定的 悲喜剧 进行中 疑问 讽刺 & 恶意 light tension 耐心 科学 害羞 伴音 | Gm | 105 |
|
||

|
Transition [TBX056 - 4] |
2'41 | Ben Haynes | Determined, upbeat, positive. Bright, playful mallets are joined by | 医疗 科学 乡村 自信 马林巴琴 手工业 公司 果断 童年 内心活动 | G | 138 |
|
|||

|
Transition - 30sec [TBX056 - 19] |
版本. | 0'30 | Ben Haynes | Determined, upbeat, positive. Bright, playful mallets are joined by | 科学 乡村 自信 马林巴琴 手工业 公司 果断 童年 内心活动 伴音 | G | 138 |
|
||

|
A Reflective Approach [CEZ4531 - 9] |
0 | 1'53 | Louis Edlinger, Andreas Suttner | Bed. Calm, descriptive, patient, methodic & neutral. Electronics, | 安静 科学 伴音 中立 原声乐器 稳定的 诞生 热带雨林 耐心 严谨 | Em | 162 |
|
||

|
Rings of Light [CEZ4370 - 1] |
1'43 | Anselm Kreuzer, Andreas Suttner | Underscore. Contant, neutral, twinkling & patient. Keyboard, synth, | 科学 稳定的 周期性的 精致 中立 耐心 下雨 伴音 通透 钢鼓 | Fm | 118 |
|
|||

|
Rings of Light Alternate [CEZ4370 - 21] |
版本. | 1'43 | Anselm Kreuzer, Andreas Suttner | Underscore. Contant, neutral, twinkling & patient. Keyboard, chimes | 稳定的 科学 周期性的 精致 中立 耐心 打击乐 下雨 简单 通透 | Fm | 120 |
|
||

|
Rings of Light Alternate 2 [CEZ4370 - 22] |
版本. | 1'43 | Anselm Kreuzer, Andreas Suttner | Underscore. Contant, neutral, twinkling & patient. Synth & hang drum. | 科学 周期性的 中立 耐心 下雨 稳定的 钢鼓 宁静 手工业 精致 | Fm | 119 |
|
||

|
Rings of Light Alternate 3 [CEZ4370 - 23] |
版本. | 1'44 | Anselm Kreuzer, Andreas Suttner | Underscore / electro minimalism. Constant, minimalist & neutral. | 稳定的 科学 稀疏 疑问 中立 下雨 简单 极简电子音乐 宁静 耐心 | Fm | 80 |
|
||

|
Reproduction 2 [CEO2068 - 16] |
1'01 | Pablo Pico | Underscore. Dreamy & suspended. Marimba & vibraphone. | 昆虫 诞生 童年 原声乐器 梦幻 科学 耐心 伴音 手工业 周期性的 | Am | 90 |
|
|||

|
Cyclic Reproduction [CEO2068 - 3] |
版本. | 1'02 | Pablo Pico | Underscore. Swarming & peaceful. Marimba & vibraphone. | 耐心 周期性的 科学 手工业 通透 叙述 固执 仙境 宁静 进行中 | Am | 89 |
|
||

|
Repetitive Experience [CEZ4484 - 7] |
1'53 | Anselm Kreuzer, Andreas Suttner | Repetitive, experimental, serious & obstinate. Light electro | 周期性的 科学 严谨 伴音 稳定的 神秘 进行中 疑问 调查研究 社会悲剧 | Fm | 150 |
|
|||

|
Repetitive Experience
[CEZ4484 - 31] |
版本. | 1'53 | Anselm Kreuzer, Andreas Suttner | Minimalist alternate version. Repetitive, experimental, serious & | 周期性的 科学 严谨 伴音 稳定的 稀疏 神秘 进行中 疑问 调查研究 | Fm | 150 |
|
||

|
Inner Adventure [CEZ4533 - 17] |
2'47 | Louis Edlinger | Underscore/bed. Organic, wet, narrative, vibrant, patient & | 医疗 原声电子 耐心 稳定的 潮湿 神秘 科学 伴音 安静 通透 | C | 85 |
|
|||

|
Inner Adventure Alternate 1 [CEZ4533 - 51] |
版本. | 2'47 | Louis Edlinger | Minimalist alternate version. Keyboard with FX & sound-design only. | 稳定的 叙述 伴音 安静 夜晚 原声电子 耐心 科学 电子键盘 精致 | C | 85 |
|
||

|
Inner Adventure Alternate 2 [CEZ4533 - 52] |
版本. | 2'19 | Louis Edlinger | Minimalist alternate version. Hook & light percussion only. | 稳定的 稀疏 伴音 潮湿 叙述 夜晚 科学 安静 通透 医疗 | C | 172 |
|
||

|
Modelization 2 [CEZ4197 - 25] |
2'17 | Elisabeth Skornik, Guy Skornik | Thorough & confident. Electronics & pizzicato strings. No drums. | 手工业 耐心 科学 电声低音 企业宣传 天气预告 稳定的 工业 弦乐乐团 自信 | D | 130 |
|
|||

|
Modelization [CEZ4197 - 5] |
版本. | 2'16 | Elisabeth Skornik, Guy Skornik | Thorough & confident. Electronics & pizzicato strings. | 科学 手工业 耐心 电声低音 企业宣传 天气预告 自信 稳定的 工业 周期性的 | D | 130 |
|
||

|
Doubt or Hesitation [CEZ4531 - 23] |
0 | 2'33 | Louis Edlinger, Andreas Suttner | Bed. Cautious, careful, methodical & attentive. Marimba, synth voice | 稳定的 进行中 耐心 科学 自然灾害 海底 严谨 悬念 疑问 马林巴琴 | Am | 162 |
|
BPM
或
KEYS